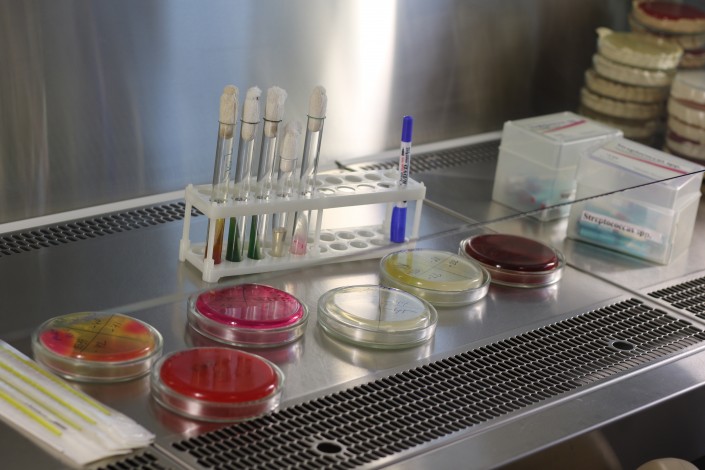

Казахстанцам советуют не заниматься самолечением антибиотиками, а врачей призывают правильно подбирать пациентам препараты, передает Tengrinews.kz.
В Астане в Президентской клинике собрали эпидемиологов, клинических специалистов и фармакологов для обсуждения глобальной проблемы. С каждым годом во всем мире усиливается устойчивость микроорганизмов к антибиотикам - противомикробным препаратам. Врачи называют это антибиотикорезистентностью. Такие инфекции, как пневмония, туберкулез или гонорея, врачам становится труднее лечить из-за снижения эффективности антибиотиков.
"Почему развивается антибиотикорезистентность? По нескольким причинам. Одна из основных - нерациональное использование антибактериальных препаратов. Это чрезмерное назначение антибиотиков в тех случаях, когда нет необходимости в назначении этих препаратов. Это вирусные инфекции, бактериальные инфекции, которые не требуют немедленного назначения препаратов. Это необоснованно длительный курс антибиотиков или короткий курс антибактериальной терапии. Имеют значение неправильно подобранные схемы приема препаратов, а также недостаточное количество исследований по производству новых антибактериальных препаратов", - пояснила заместитель директора по лечебной работе Больницы Медицинского центра Управления делами Президента РК Раушан Карабаева.
По мнению Раушан Карабаевой, вышеназванные причины не позволяют контролировать инфекции.
"Например, хорошо проведенная операция может быть нивелирована присоединением пневмонии или сепсисом, и больной погибает от осложнений. Не только пациенты занимаются самолечением, но и мы, врачи, не всегда правильно назначаем эти препараты. Должна быть ответственность и врача, и пациента. Антибиотики сейчас в свободной и бесконтрольной продаже. Это привело к тому, что каждый человек может сам себе назначить препарат. Это неправильно", - отмечает врач Президентской клиники Раушан Карабаева.
Медики заявляют, что самолечение антибиотиками, неправильно подобранный препарат врачом и приводит к устойчивости штамма возбудителей инфекции к действию антибиотиков. Врачи рассказали о последствиях приема препаратов, которые больной сам себе "прописал".
"Он может подобрать неправильный антибиотик, который имеет природную чувствительность к определенному виду микроорганизмов, то есть этот антибиотик не будет действовать. Помимо этого, антибиотики имеют массу побочных эффектов. Они могут проявиться у пациента, и это страшно. Антибиотики влияют на печень, почки, на желудочно-кишечный тракт", - предупредила Раушан Карабаева.
Для того чтобы начать лечение антибиотиками, нужно выявить возбудителя той или иной инфекции, определить чувствительность к тем или иным антибиотикам. Только тогда врач может назначить лечение антибиотиками, считает старший врач микробиологической лаборатории Больницы Управления делами Президента РК Жанар Ибраева.
"В лаборатории Президентской клиники выявляют возбудителей, которые являются причиной заболевания: правильно определяют его вид, определяют правильно группу антибиотика, которую можно применять для лечения. Чтобы определить эти антибиотики, мы применяем несколько методов. Есть ручной метод, когда применяются диски с определенной концентрацией антибиотиков, и есть бактериологический анализатор. Наша лаборатория ежедневно может выполнить около 50-60 исследований", - пояснила Жанар Ибраева.
Данная лаборатория работает на основе международных стандартов. "У нас используется оборудование, которое позволяет говорить, что наши исследования высококачественные. Не зря ВОЗ поднимает проблему - существует уже много микроорганизмов, которые не поддаются лечению, то есть они устойчивы ко всем имеющимся антибиотикам в мире. Последние несколько лет нет выпуска новых антибиотиков. Над этим, конечно, многие страны работают", - выразила мнение старший врач микробиологической лаборатории Президентской больницы.
По официальным данным, по всему миру более 25 тысяч пациентов могут умереть от антибиотикорезистентности.
"Мы должны обучать врачей, пациентов, чтобы правильно использовали антибиотики. Путем пропаганды, правильного использования антибиотиков мы можем только сдерживать антибиотикорезистентность. Мы уже сейчас врачей призываем не назначать при вирусных инфекциях антибиотики, а прописывать противовирусные препараты", - отметила заведующая клинико-фармакологическим отделением Больницы Управления делами Президента РК Алтын Нурпеисова.